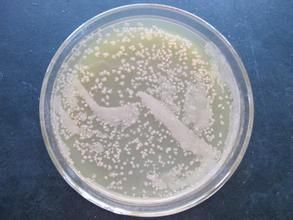
微生物菌種

飼料發酵菌種
簡介
發酵飼料是以微生物、複合酶為生物飼料發酵劑菌種,將飼料原料轉化為微生物菌體蛋白、生物活性小肽類胺基酸、微生物活性益生菌、複合酶製劑為一體生物發酵飼料。該產品不但可以彌補常規飼料中容易缺乏的胺基酸,而且能使其它粗飼料原料營養成份迅速轉化,達到增強消化吸收利用效果。 微生物菌種
微生物菌種一、發酵對象與分類
1、發酵全價飼料、濃縮料取出全價飼料(使用濃縮料的按配好的全價飼料計算)按下面配比進行發酵。
2、發酵棉粕菜粕脫毒代替豆粕,另見說明書。
3、發酵生物豆粕代替魚粉:可以適當加大菌種使用量,直接發酵豆粕轉化成生物活性小肽後添加,另見說明書。
二、發酵方法
(以發酵1000公斤發酵飼料為例)1、 發酵飼料原料與配方:配製好的發酵飼料1000公斤,水350-400公斤(夏天350,冬天400),菌種飼料發酵劑5公斤,100-200克納豆菌。2、 製作稀釋活化發酵液:將菌種5公斤飼料發酵劑和100-200克納豆菌倒入350-400公斤水中攪拌均勻製成活化發酵液。3、 將製成的活化發酵液與1000公斤發酵飼料混合均勻,濕度以手捏成團不滴水,一觸即散為宜。有攪拌機的大型養殖場將活化發酵液慢慢加入飼料中攪拌均勻即可;沒有攪拌機的養殖戶將活化發酵液慢慢少量噴到飼料上,用鐵鍬攪拌均勻,注意:不能有團塊、水結塊,用手將團塊、水結塊搓散攪拌均勻。 4、大型養殖場可以將配置好的飼料在地面壓實堆成垛或者裝入水泥池壓實,用塑膠薄膜密封或者使用厚實的不透氣的塑膠碎團塊、水結塊。
三、使用功效:
1、本品占全價配合飼料的5-30%,一般情況下為10%合適,配製母豬飼料時,建議用量不超過20%。本品按比例配合均勻後飼喂,現配現喂,可乾餵也可濕喂,自由飲水。2、打開包裝袋一角可與粉料或顆粒料等不同料型搭配飼餵。
3、本品可作為乳豬斷奶前後的誘食飼料,飼餵後乳豬可平穩度過斷奶期,防止出現應激反應和腹瀉。
4、遇到仔豬黃白痢或生長緩慢的僵豬可適當將發酵飼料添加比例增加至20%添加,可有效防治仔豬黃白痢,促進僵豬快速生長。
5、母豬產後不食或泌乳不足或乳豬黃白痢,可將母豬飼料中發酵飼料添加比例增加至20%。
四、注意事項:
1、開袋後儘快用完,本品顏色稍有變化、有結塊不影響使用性能;2、初始飼餵時,因適口性好,而乳豬仔豬消化機能尚不健全,要防止乳豬仔豬採食過飽而引起消化不良,採用少餵多餐3-5天過渡即可;
3、5-9月份高溫天氣,現配現喂,1-2天用完;如混本品後存放時間較長,請將發酵飼料添加比例減少到5%,以防止水分超標發熱。
生物肥發酵菌種
生物有機肥是有機固體廢物(包括有機垃圾、秸稈、畜禽糞便、餅粕、農副產品和食品加工產生的固體廢物)經生物肥菌種發酵、除臭和完全腐熟後加工而成的有機肥料。
生物有機肥的種類:
農家肥:堆肥,沼渣等。商品生物有機肥:商品化生產的生物有機肥。即農家肥商品化生產後的產物。
生物有機肥的優點:
1 生物有機肥與化肥相比:1) 生物有機肥營養元素齊全;化肥營養元素只有一種或幾種。
2) 生物有機肥能夠改良土壤;化肥經常使用會造成土壤板結。
3) 生物有機肥能提高產品品質;化肥施用過多導致產品品質低劣。
4) 生物有機肥能改善作物根際微生物群,提高植物的抗病蟲能力;化肥則是作物微生物群體單一,易發生病蟲害。
5) 生物有機肥能促進化肥的利用,提高化肥利用率;化肥單獨使用易造成養分的固定和流失。
2 生物有機肥與精製有機肥相比:
精製有機肥是畜禽糞便經過烘乾、粉碎後包裝出售的商品有機肥。
1)生物有機肥完全腐熟,不燒根,不爛苗;精製有機肥未經腐熟,直接使用後在土壤里腐熟,會引起燒苗現象。
2)生物有機肥經高溫腐熟,殺死了大部分病原菌和蟲卵,減少病蟲害發生;精製有機肥未經腐熟,在土壤中腐熟時會引來地下害蟲。
3)生物有機肥中添加了有益菌,由於菌群的占位效應,減少病害發生;精製有機肥由於高溫烘乾,殺死了裡面的全部微生物。
4)生物有機肥養分含量高;精製有機肥由於高溫處理,造成了養分損失。
5)生物有機肥經除臭,氣味輕,幾乎無臭;精製有機肥未經除臭,返潮即出現惡臭。
3 生物有機肥與農家肥的區別:
1)生物有機肥完全腐熟,蟲卵死亡率達到97%以上;農家肥堆放簡單,蟲卵死亡率低。
2)生物有機肥無臭;農家肥有惡臭。
3)生物有機肥施用方便,均勻;農家肥施用不方便,肥料施用不均勻。
4 生物有機肥與生物菌肥的區別:
1)生物有機肥價格便宜,每噸在800元左右;生物菌肥價格昂貴,每噸上萬元。
2)生物有機肥含有功能菌和有機質,能改良土壤促進被土壤固定養分的釋放;生物菌肥只含有功能菌,通過功能菌來促進土壤固定肥料的利用。
3)生物有機肥的有機質本身就是功能菌生活的環境,施入土壤後容易存活;而生物菌肥的功能菌可能不適合有的土壤環境。
生物有機肥國家標準
中華人民共和國農業行業標準(NY 884—2004)生物有機肥
2005-01-04發布 2005-02-01實施
中華人民共和國農業部 發布
前 言
本標準由中華人民共和國農業部種植業管理司提出。本標準起草單位:農業部微生物肥料質量監督檢驗測試中心、中國農業科學院土壤肥料研究所、廣州益元生物科技有限公司技術部。
本標準主要起草人:申望平、沈德龍、李俊、姜昕、陳慧君、曹鳳明、關大偉、李力。
生物有機肥
1 範圍本標準規定了生物有機肥的要求、檢驗方法、 檢驗規則、標識、包裝、運輸和貯藏。
本標準適用於生物有機肥。
2 規範性引用檔案
下列檔案中的條款通過本標準的引用而成為本標準的條款。凡是注日期的引用檔案,其隨後所有的修改單(不包括勘誤的內容)或修訂版均不適用於本標準,然而,鼓勵根據本標準達成協定的各方研究是否可使用這些檔案的最新版本。凡是不注日期的引用檔案,其最新版本適用於本標準。
GB 8170—1987 數值修約規則
GB 18877—2002 有機-無機復混肥料
GB/T 1250-1989 極限數值的表述方法和判定方法
GB/T 19524.1—2004 肥料中糞大腸菌群的測定
GB/T 19524.2—2004 肥料中蛔蟲卵死亡率的測定
NY 525—2002 有機肥料
NY/T 798—2004 複合微生物肥料
3 術語和定義
下列術語和定義適用於本標準。
生物有機肥 指特定功能微生物與主要以動植物殘體(如畜禽糞便、農作物秸稈等)為來源並經無害化處理、腐熟的有機物料複合而成的一類兼具微生物肥料和有機肥效應的肥料。
4 要求
4.1 菌種
使用的微生物菌種應安全、有效,有明確來源和種名,本標準採用廣州益元生物科技菌種。
4.2 外觀(感官):粉劑產品應鬆散、無惡臭味;顆粒產品應無明顯機械雜質、大小均勻、無腐敗味。 4.3 技術指標
生物有機肥產品的各項技術指標應符合表1的要求。
表1 生物有機肥產品技術要求
-----------------------------------------------------
項 目 粉 劑 顆 粒
-----------------------------------------------------
有效活菌數(cfu) ,億/g ≥ 0.20 0.20
有機質(以乾基計),% ≥ 25.0 25.0
水分,% ≤ 30.0 15.0
pH值 5.5~8.5 5.5~8.5
糞大腸菌群數,個/g(mL) ≤ 100 100
蛔蟲卵死亡率,% ≥ 95 95
有效期,月 ≥ 6 6
-----------------------------------------------------
4.4 生物有機肥產品中As、Cd、Pb、Cr、Hg含量指標應符合NY/T 798—2004中4.2.3的規定。
4.5 若產品中加入無機養分,應明示產品中總養分含量,以(N P2O5 K2O)總量表示。
5 抽樣方法
對每批產品進行抽樣檢驗,抽樣過程應避免雜菌污染。
5.1 抽樣工具
抽樣前預先備好無菌塑膠袋(瓶)、金屬勺、剪刀、抽樣器、封樣袋、封條等工具。
5.2 抽樣方法和數量
在產品庫中抽樣,採用隨機法抽取。抽樣以袋為單位,隨機抽取5~10袋。在無菌條件下,從每袋中取樣200~300g,然後將所有樣品混勻,按四分法分裝3份,每份不少於500g。
6 試驗方法
6.1 外觀
用目測法測定:取少量樣品放在白色搪瓷盤(或白色塑膠調色板)中,仔細觀察樣品的形狀、質地,應符合4.2的要求。
6.2 有效活菌數測定
應符合NY/T 798—2004中5.3.2的規定。
6.3 有機質的測定
應符合NY 525—2002中5.2的規定。
6.4 水分測定
應符合NY/T 798—2004中5.3.5的規定。
6.5 pH值測定
應符合NY/T 798—2004中5.3.7的規定。
6.6 糞大腸菌群數的測定
應符合GB/T 19524.1—2004的規定。
6.7 蛔蟲卵死亡率的測定
應符合GB/T 19524.2—2004的規定。
6.8 As、Cd、Pb、Cr、Hg的測定
應符合GB 18877—2002中5.12~5.17的規定。
6.9 N P2O5 K2O含量測定
應符合NY 525—2002中5.3~5.5的規定。
7 檢驗規則
7.1 檢驗分類
7.1.1 出廠檢驗(交收檢驗)
產品出廠時,應由生產廠的質量檢驗部門按表1進行檢驗,檢驗合格並簽發質量合格證的產品方可出廠。出廠檢驗時不檢有效期。
7.1.2 型式檢驗(例行檢驗)
一般情況下,一個季度進行一次。有下列情況之一者,應進行型式檢驗。
a) 新產品鑑定;
b) 產品的工藝、材料等有較大更改與變化;
c) 出廠檢驗結果與上次型式檢驗有較大差異時;
d) 國家質量監督機構進行抽查。
7.2 判定規則
本標準中產品技術指標的數字修約應符合GB 8170的規定;產品質量合格判定應符合GB/T 1250中修約值比較法的規定。
具下列任何一條款者,均為合格產品
a) 產品全部技術指標都符合標準要求;
b) 在產品的外觀、pH值、水分檢測項目中,有1項不符合標準要求,而產品其它各項指標符合標準要求。 具下列任何一條款者,均為不合格產品
a) 產品中有效活菌數不符合標準要求;
b) 有機質含量不符合標準要求;
c) 糞大腸菌群數不符合標準要求;
d) 蛔蟲卵死亡率不符合標準要求;
e) As、Cd、Pb、Cr、Hg中任一含量不符合標準要求;
f) 產品的外觀、pH值、水分檢測項目中,有2項以上不符合標準要求。
8 標識、包裝、運輸和貯藏
生物有機肥的標識、包裝、運輸和貯藏應符合NY/T 798—2004中第7章的規定。

